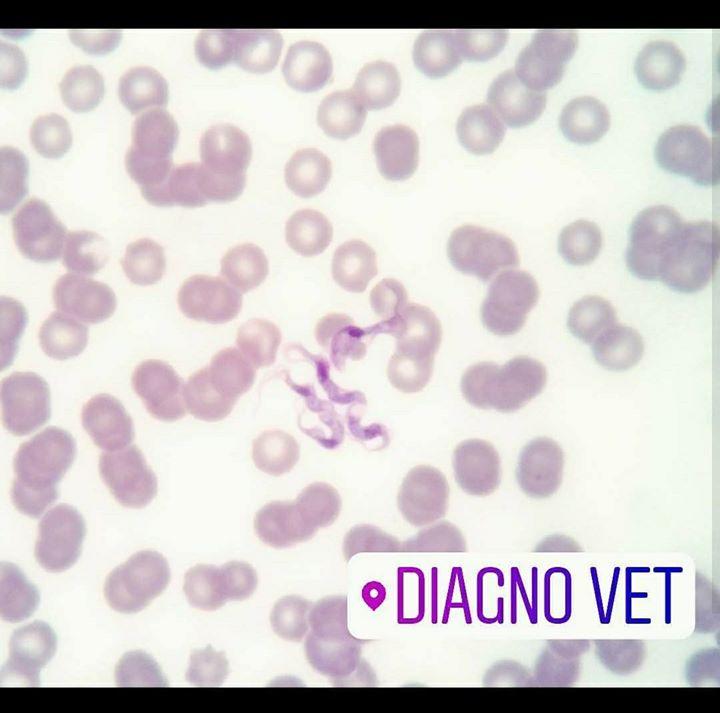
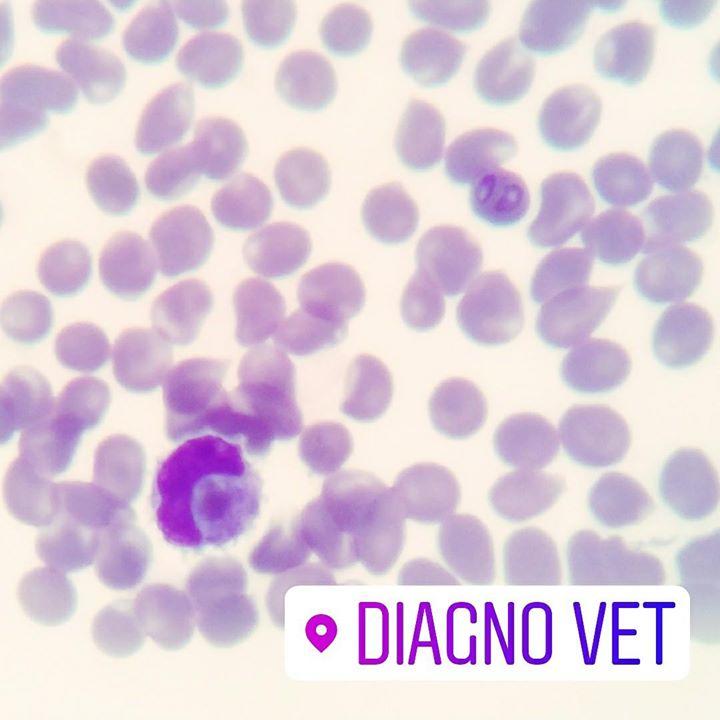

🔶 As “doenças do carrapato” são causadas …
sandro2018-03-16T03:27:05+00:00🔶 As “doenças do carrapato” são causadas por parasitas do sangue, tecnicamente chamados hemoparasitas 🔶 Entre eles, temos o protozoário Hepatozoon canis, que também é transmitido pelo carrapato do cão, Rhipicephalus (Boophilus) sanguineus 🔶 A transmissão não ocorre pela picada, mas quando o cão ingere o carrapato 🔶 Os sinais clínicos podem ser brandos ou graves, como febre, anorexia, perda de peso, fraqueza e até paralisia dos membros posteriores 🔶 Alterações laboratoriais incluem leucocitose moderada, anemia, trombocitopenia, hipoalbuminemia, hiperglobulinemia 🔶 O diagnóstico é geralmente feito pela observação do parasita em neutrófilos e monócitos em esfregaços sanguíneos periféricos 🔶 Somente um médico veterinário pode diagnosticar e tratar adequadamente esta doença 🔶 🔶 🔶 🔶 #hemoparasitas #hematozoarios #carrapatos #diagnósticoveterinário #doençadocarrapato #hematologiaveterinaria #parasitologiaveterinaria #maquinanaofazhemograma #pcv #medvet #vetbr #areatecnicadiagnovet